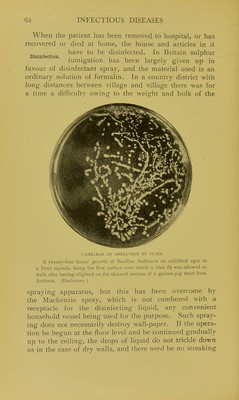

The prevention of infectious diseases, being the Lane lectures delivered at Cooper Medical College, San Francisco, in August, 1906, and revised for publication / by John C. M'Vail.
- John McVail
- Date:
- 1907
Licence: In copyright
Credit: The prevention of infectious diseases, being the Lane lectures delivered at Cooper Medical College, San Francisco, in August, 1906, and revised for publication / by John C. M'Vail. Source: Wellcome Collection.
Provider: This material has been provided by London School of Hygiene & Tropical Medicine Library & Archives Service. The original may be consulted at London School of Hygiene & Tropical Medicine Library & Archives Service.
1/326